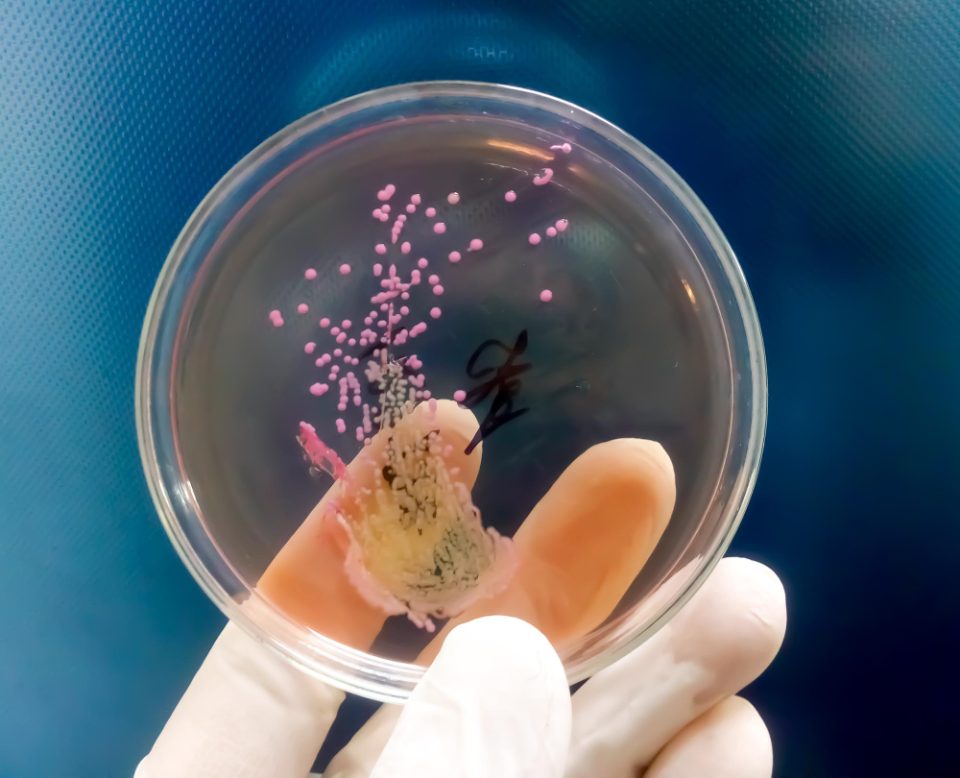

Бактерии отпорни на антибиотици, откриени длабоко во ледена пештера, се отпорни на до 10 различни видови на лекот – поттикнувајќи страв од супербактерии.
Неодамнешна бактериска студија откри организми зачувани во слој мраз стар 5.000 години во ледената пештера Скаришоара во романските планини Апусени, која се одликува со голема отпорност на современите антибиотици. Организмите се размножувале во екстремни услови, давајќи им до 100 гени поврзани со отпорност, откриле истражувачите, и покрај тоа што постоеле милениуми пред пронаоѓањето на виталниот лек.
Сепак, научниците објаснија дека и покрај стравувањата во последните години дека ваков отпор би можел да го врати човештвото во „мрачните векови“, најновото откритие би можело да биде од витално значење за медицината.
Истражувачкиот тим од Романија објасни дека бактериите еволуирале за да се прилагодат на сите најекстремни услови на Земјата, од жешка топлина до температури далеку под нулата. Ледените пештери се само една од средините каде што живеат низа микроорганизми кои претставуваат извор на генетска разновидност што сè уште не е опширно проучен.
Тие откриле дека ова би можело да биде можност за развој на нови начини за спречување на порастот на отпорноста на антибиотици и проучување на тоа како отпорноста природно се развива и се шири.
Раководителот на студијата, д-р Кристина Пуркареа, виш научник на Институтот за биологија во Букурешт, изјави дека бактерискиот сој, наречен Psychrobacter SC65A.3, може да го инхибира растот на потенцијално опасни бактерии.
„Бактерискиот сој Psychrobacter SC65A.3 изолиран од Ледената пештера Скарисоара, и покрај неговото античко потекло, покажува отпорност на повеќе современи антибиотици и носи над 100 гени поврзани со отпорност“, вели таа.
„Но, може да го инхибира и растот на неколку големи „супербактерии“ отпорни на антибиотици и покажа важни ензимски активности со важен биотехнолошки потенцијал.“
Д-р Пуркареа објасни дека Psychrobacter SC65A.3 е сој од родот Psychrobacter, што се бактерии прилагодени на ладни средини. Некои видови можат да предизвикаат инфекции и кај луѓето и кај животните. Бактеријата има биотехнолошки потенцијал, но профилите на отпорност на антибиотици на бактериите се во голема мера непознати.
„Проучувањето на микроби како што е Psychrobacter SC65A.3 пронајдени од милениумски стари ледени наслаги во пештерски мраз открива како отпорноста на антибиотици еволуирала природно во животната средина, долго пред да се користат модерните антибиотици“, додава таа.
Истражувачкиот тим дупчеше ледено јадро од 25 метри од областа на пештерата позната како Голема сала, што претставува временска рамка од 13.000 години. За да се избегне контаминација, фрагментите од мраз земени од јадрото беа ставени во стерилни кеси и замрзнати на патот назад кон лабораторијата.
Истражувачкиот тим изолираше различни бактериски соеви и го секвенционираше нивниот геном во лабораторијата за да утврди кои гени му овозможуваат на сојот да преживее на ниски температури, а кои даваат антимикробна отпорност и активност.
Тие тестираа отпорност на сојот SC65A на 28 антибиотици од 10 класи кои рутински се користат или се резервирани за лекување на бактериски инфекции. Тестираните лекови вклучуваа антибиотици за кои претходно е идентификувано дека поседуваат гени за отпорност или мутации кои им даваат способност да се спротивстават на ефектите на лековите.
На тој начин, тие би можеле да тестираат дали предвидените механизми се преведуваат во мерлива отпорност. Д-р Пуркареа вели: „10-те антибиотици на кои откривме отпорност се широко користени во орални и инјективни терапии што се користат за лекување на низа сериозни бактериски инфекции во клиничката пракса“.
Болести како што се туберкулоза (ТБ), колитис и инфекции на уринарниот тракт (УТИ) може да се третираат со некои од антибиотиците на кои истражувачите откриле отпорност, вклучувајќи рифампицин, ванкомицин и ципрофлоксацин.
SC65A.3 е првиот сој Psychrobacter за кој е пронајдена отпорност на одредени антибиотици – вклучувајќи триметоприм, клиндамицин и метронидазол. Овие антибиотици се користат за лекување на уринарни инфекции, инфекции на белите дробови, кожата или крвта и репродуктивниот систем.
Профилот на отпорност на SC65A.3 сугерира дека соевите способни да преживеат во ладни средини би можеле да дејствуваат како „резервоари“ на гени за отпорност, кои се специфични ДНК секвенци што им помагаат да преживеат изложеност на лекови, според истражувачкиот тим. Тие велат дека бактериските соеви како оној што го испитале носат и закана и ветување.
„Ако топењето на мразот ги ослободи овие микроби, овие гени би можеле да се прошират на современите бактерии, додавајќи го глобалниот предизвик на отпорноста на антибиотици, вели д-р Пуркареа.
„Од друга страна, тие произведуваат уникатни ензими и антимикробни соединенија кои би можеле да инспирираат нови антибиотици, индустриски ензими и други биотехнолошки иновации“.
Во геномот на Psychrobacter SC65A.3, истражувачите пронајдоа речиси 600 гени со непознати функции, што укажува на сè уште неискористен извор за откривање нови биолошки механизми. Анализата на геномот, објавена во списанието Frontiers in Microbiology, исто така откри 11 гени кои се потенцијално способни да убијат или да го спречат растот на други бактерии, габи и вируси.
извор:нетпрес
фото:Freepik







